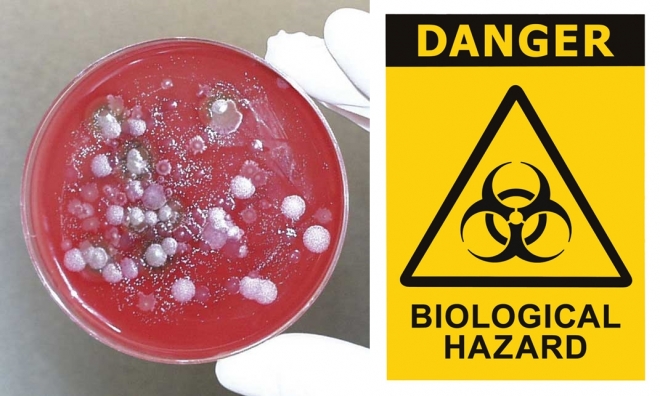

블라디미르 푸틴 러시아 대통령. AP 연합뉴스
러시아 관영 스푸트니크 통신에 따르면 러시아 국방부는 7일(현지시간) “우크라이나 우익 극단주의 단체 ‘아조프 부대’와 우크라이나 보안국(SBU)이 ‘하르키우 물리학·기술연구소’의 실험용 원자로를 폭파할 계획을 세우고 있다”고 말했다.
러 “우크라, 실험용 원자로 폭파 자작극 계획” 주장

하르키우 물리학·기술연구소
위키피디아
1932년 소련의 첫 핵분열 실험이 이곳에서 수행됐으며, 소련 최초의 핵폭탄 개발도 담당했다.
러시아 국방부는 우크라이나 측이 연구소 내 실험용 원자로를 폭파한 뒤 “러시아군의 미사일 공격을 당했다고 주장하려는 것”이라고 주장했다.
또 “외신 기자들이 지난 6일 하르키우에 도착했다. 우크라이나 측의 도발 행위를 취재해서 러시아에 책임을 떠넘기려는 것”이라고 의혹을 제기했다.
그러면서 “이 지역을 방사능으로 오염시킬 수 있는 도발 행위”라고 비난했다.
러, 원전 확보 뒤 “우크라, 핵무기 개발 시도”

유튜브 캡처 로이터 연합뉴스
우크라이나는 물론 유럽 최대의 원자력발전소로 평가되는 남동부 자포리자 원자력발전소 직원들의 거주지인 에네르호다르 시에 설치된 감시 카메라가 4일 폭발 섬광을 포착했다.
유튜브 캡처 로이터 연합뉴스
유튜브 캡처 로이터 연합뉴스
스푸트니크 통신은 전날 ‘러시아인 소식통’을 인용해 우크라이나가 핵무기 개발을 시도했다는 의혹을 보도했다.
러시아군이 지난 4일 우크라이나 자포리자 원자력 발전소를 공격한 것은 우크라이나의 핵무기 개발 시도와 연관이 있다며, 핵무기 개발을 추진한 흔적을 지우려던 우크라이나 측과 증거를 확보하려는 러시아군이 충돌했다고 주장했다.
러시아군은 자포리자 원전 단지에 포격을 가해 건물에 화재를 내면서 전 세계적인 우려를 산 바 있다.
이때도 러시아 국방부는 자포리자 원전 단지 공격이 우크라이나 사보타주(의도적 파괴행위) 그룹의 소행이라고 주장했다.
자포리자 원전은 우크라이나에서 가동 중인 원자로 15기 중 6기를 보유한 대규모 단지이며 우크라이나 전력 공급의 4분의 1을 담당하고 있다. 단일 단지로는 유럽 최대 규모의 원자력 발전소이기도 하다.
스푸트니크 통신이 인용한 익명의 소식통은 우크라이나 정부가 체르노빌 원전의 방사성 물질을 이용해 이른바 ‘더러운 폭탄’(dirty bomb)을 만들려 했다는 주장도 내놨다.
더러운 폭탄은 재래식 폭탄에 방사성 물질을 넣어 넓은 지역을 오염시키는 무기를 뜻한다.
러시아는 침공 둘째날인 지난달 25일 벨라루스 국경을 통해 우크라이나 수도 키이우를 향해 진격하던 경로에서 먼저 체르노빌 원전을 장악했다.
원전 확보 통해 ‘전쟁 명분쌓기+에너지 통제’

EPA 연합뉴스 자료사진
추가 방호벽이 설치된 체르노빌 원전
EPA 연합뉴스 자료사진
EPA 연합뉴스 자료사진
러시아가 우크라이나 내 원전을 군사작전 목표로 삼은 이유는 일단 명분쌓기와 전력공급 통제 때문이다.
러시아 관영 매체 보도처럼 우크라이나의 핵무장 시도를 막기 위해 군사적 개입이 불가피했다는 주장을 뒷받침할 명분을 쌓으려는 의도다.
블라디미르 푸틴 러시아 대통령은 지난달 24일 우크라이나에 대한 군사작전을 명령하면서 우크라이나 내 극단세력이 핵무기를 보유하려 한다고 주장했다. 그는 같은 달 21일 대국민 담화에서도 우크라이나가 자체 핵무장을 추진하려 하고 있으며, 미국도 우크라이나 영토에 무기를 배치할 계획이 있다고 말한 바 있다.
또 원전을 확보해 작동을 중단시키거나 전력 공급을 끊는다면 우크라이나의 사회기반시설은 물론 군사 행동에도 지장을 줄 수 있다.
우크라 자작극 언급 배경엔 실제 파괴 가능성?

엄청난 양의 방사능 누출로 죽음의 땅 된 체르노빌
35년 전인 1986년 4월 26일 발생한 체르노빌 원전 폭발사고는 원전의 위험성을 인식시킨 충격적인 사건이었다. 방사능 피폭 위험이 사라지기까지는 900년 이상이 걸릴 것이라는 예상까지 나오고 있다.
원전이 파괴되거나 손상이 가해지면 방사능 누출 위험이 커지는 것은 불 보듯 뻔하다.
방사능 누출이 현실화하면 우크라이나는 즉각적인 피해는 물론 거의 영구적인 피해를 입게 된다.
러시아군을 격퇴하고 전쟁에서 승리하더라도 우크라이나 영토와 국민들은 방사능 누출 피해를 안고 살아가야 한다.
이처럼 돌이킬 수 없는 군사적 모험을 감행하면 러시아는 전인류적 비난에 직면할 수밖에 없게 된다.
러시아 측이 우크라이나의 자작극을 계속 언급하는 배경에 이러한 군사적 무리수를 둘 가능성이 있기 때문 아니냐는 우려가 나온다.
러 “우크라 내 생물학 무기 개발 흔적” 주장도
탄저균 배양기
위키피디아·123rf
러시아 국방부의 이고리 코나셴코프 대변인은 6일 “정밀 타격이 가능한 장거리 무기로 우크라이나 내 방위 산업 시설을 공격할 것”이라고 밝히면서 이번 특별군사작전(우크라이나 침공) 과정에서 우크라이나군의 ‘군사 생물학 프로그램’ 흔적을 확인했다고 주장했다.
코나셰코프 대변인은 “우크라이나의 특정 실험실에서 생물학 무기 성분 개발이 이뤄지는 것을 확인했다”면서 “이들 실험 시설은 미국으로부터 자금 지원을 받고 있었다”고 주장했다.
이에 대한 증거로 우크라이나 생물학 무기 실험실에서 일한 직원으로부터 받은 서류를 제시했다.
미 군사전문가 “러, 생화학무기 사용 명분쌓기 시도”러시아의 ‘생물학 무기’ 언급은 우크라이나에서 핵 공격보다 생화학 무기 위험성이 커지고 있다는 서방 군사전문가의 경고가 나온 터라 더욱 주목된다.
앤디 웨버 전 미 국방부 핵·생화학방어프로그램 차관보는 5일 영국 텔레그래프에 러시아가 생화학 무기 사용 명분을 만들려고 거꾸로 위협을 지어낼 것이라고 우려했다.
그는 특히 러시아가 평화시에도 생화학 무기를 사용한 사례가 있기에 우크라이나에서 쓰지 않을 이유가 없다고 지적했다.
러시아는 방사성 물질이나 신경작용제 노비촉을 푸틴 정적 암살에 활용했다는 의혹을 받고 있고, 모스크바 극장에서 인질극을 벌이는 체첸 반군을 진압하기 위해 신경가스를 쓰는 바람에 인질들까지 사망한 사례도 있다.
웨버 전 차관보의 지적대로 세르게이 라브로프 러시아 외무장관은 이미 유엔본부 연설에서 미국이 우크라이나의 비밀 생화학 연구소의 통제권을 잃을까 우려하고 있다고 주장했다.
시리아 정부도 화학무기 공격 당시 ISIS(이슬람국가 IS의 옛 이름) 등에게 책임을 돌렸다.
또 화학무기의 경우 즉각적인 효과가 크지만 사용 흔적이 비교적 명확한 데 비해 생물학무기의 경우 서서히 그 효과가 나타나기 때문에 공격 자체를 감지하기도 어렵고 사용 주체를 추적하는 것도 쉽지 않다.
Copyright ⓒ 서울신문 All rights reserved. 무단 전재-재배포, AI 학습 및 활용 금지